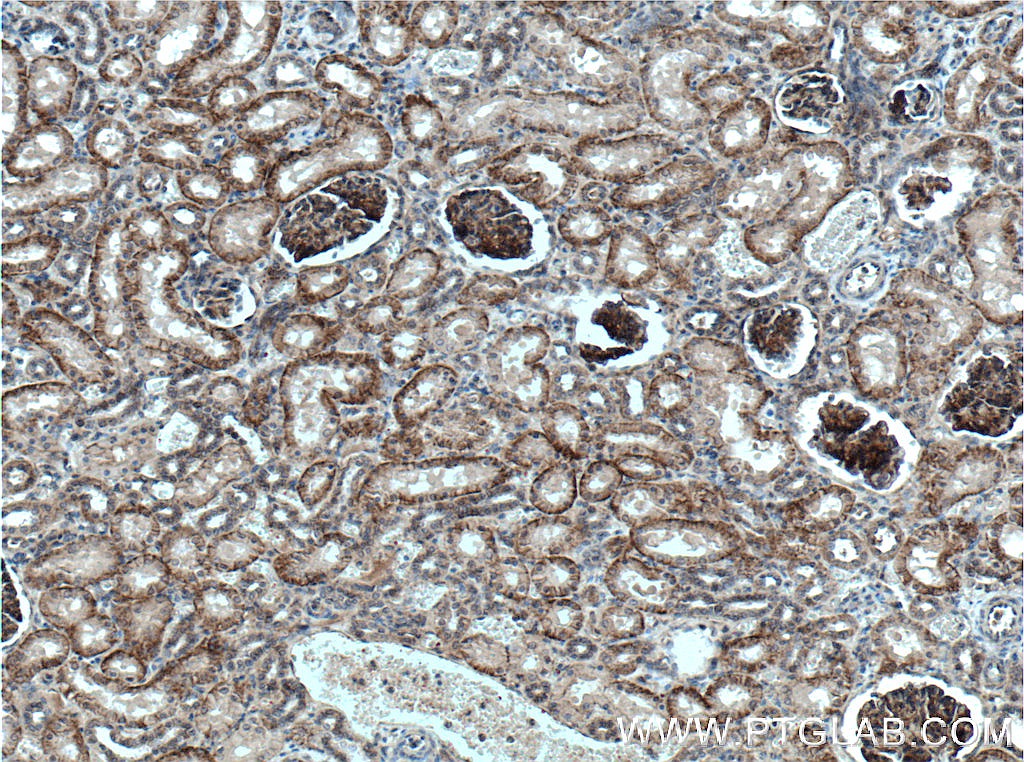

验证数据展示
经过测试的应用
| Positive WB detected in | rat kidney tissue, HAP1 cells, Jurkat cells, mouse kidney tissue, RAW 264.7 cells |
| Positive IHC detected in | human tonsillitis tissue, human kidney tissue, human breast cancer tissue Note: suggested antigen retrieval with TE buffer pH 9.0; (*) Alternatively, antigen retrieval may be performed with citrate buffer pH 6.0 |
推荐稀释比
| 应用 | 推荐稀释比 |
|---|---|
| Western Blot (WB) | WB : 1:1000-1:3000 |
| Immunohistochemistry (IHC) | IHC : 1:500-1:2000 |
| It is recommended that this reagent should be titrated in each testing system to obtain optimal results. | |
| Sample-dependent, Check data in validation data gallery. | |
产品信息
27171-1-AP targets Nectin-2/CD112 in WB, IHC, IF, ELISA applications and shows reactivity with human, mouse, rat samples.
| 经测试应用 | WB, IHC, ELISA Application Description |
| 文献引用应用 | WB, IHC, IF |
| 经测试反应性 | human, mouse, rat |
| 文献引用反应性 | human, mouse, rat |
| 免疫原 |
CatNo: Ag26040 Product name: Recombinant human Nectin 2 protein Source: e coli.-derived, PGEX-4T Tag: GST Domain: 32-235 aa of BC003091 Sequence: QDVRVQVLPEVRGQLGGTVELPCHLLPPVPGLYISLVTWQRPDAPANHQNVAAFHPKMGPSFPSPKPGSERLSFVSAKQSTGQDTEAELQDATLALHGLTVEDEGNYTCEFATFPKGSVRGMTWLRVIAKPKNQAEAQKVTFSQDPTTVALCISKEGRPPARISWLSSLDWEAKETQVSGTLAGTVTVTSRFTLVPSGRADGVT 种属同源性预测 |
| 宿主/亚型 | Rabbit / IgG |
| 抗体类别 | Polyclonal |
| 产品类型 | Antibody |
| 全称 | poliovirus receptor-related 2 (herpesvirus entry mediator B) |
| 别名 | Nectin-2, Nectin cell adhesion molecule 2, Nectin 2, HVEB, Herpesvirus entry mediator B |
| 计算分子量 | 58 kDa |
| 观测分子量 | 60-70 kDa |
| GenBank蛋白编号 | BC003091 |
| 基因名称 | Nectin-2/CD112 |
| Gene ID (NCBI) | 5819 |
| RRID | AB_2880784 |
| 偶联类型 | Unconjugated |
| 形式 | Liquid |
| 纯化方式 | Antigen affinity purification |
| UNIPROT ID | Q92692 |
| 储存缓冲液 | PBS with 0.02% sodium azide and 50% glycerol, pH 7.3. |
| 储存条件 | Store at -20°C. Stable for one year after shipment. Aliquoting is unnecessary for -20oC storage. |
背景介绍
Nectin 2, also named as PVRL2, CD112, HVEB, PRR2 and PVRR2, is an adhesion molecule widely expressed in cell lines of different lineages, including hematopoietic, neuronal, endothelial and epithelial cells. CD112 belongs to a new family of immunoglobulin-like molecules that includes four members (CD111, CD112, PRR3 and CD155) sharing an ectodomain made of three Ig domains, of V and C types. CD112 is expressed in the myelo-monocytic and megakaryocytic hematopoietic lineages and the function in hematopoiesis is currently unknown. CD112 is an intercellular homophilic adhesion. CD112 localizes specifically at adherents junctions via its cytoplasmic interaction with the scaffold F-actin binding protein afadin. Disruption of the murine CD112 gene leads to infertility of male mice with morphologically aberrant spermatozoa. CD112 mediates entry of some alphaherpesvirus mutants (also named HveB) via its V domain. CD112 is involved in cell to cell spreading of viruses.
实验方案
| Product Specific Protocols | |
|---|---|
| IHC protocol for Nectin-2/CD112 antibody 27171-1-AP | Download protocol |
| WB protocol for Nectin-2/CD112 antibody 27171-1-AP | Download protocol |
| Standard Protocols | |
|---|---|
| Click here to view our Standard Protocols |
发表文章
| Species | Application | Title |
|---|---|---|
Mucosal Immunol Alpha-hemolysin of uropathogenic Escherichia coli induces GM-CSF-mediated acute kidney injury. | ||
J Transl Int Med Lipid-related protein NECTIN2 is an important marker in the progression of carotid atherosclerosis: An intersection of clinical and basic studies. | ||
iScience Proteomic and single-cell landscape reveals novel pathogenic mechanisms of HBV-infected intrahepatic cholangiocarcinoma | ||
Sci Rep Single-cell RNA sequencing unveils tumor heterogeneity and immune microenvironment between subungual and plantar melanoma | ||
Cancer Lett Histone Lactylation Dynamics: Unlocking the Triad of Metabolism, Epigenetics, and Immune Regulation in Metastatic Cascade of Pancreatic Cancer | ||
Neurosci Bull Dorsal CA1 NECTIN3 Reduction Mediates Early-Life Stress-Induced Object Recognition Memory Deficits in Adolescent Female Mice |